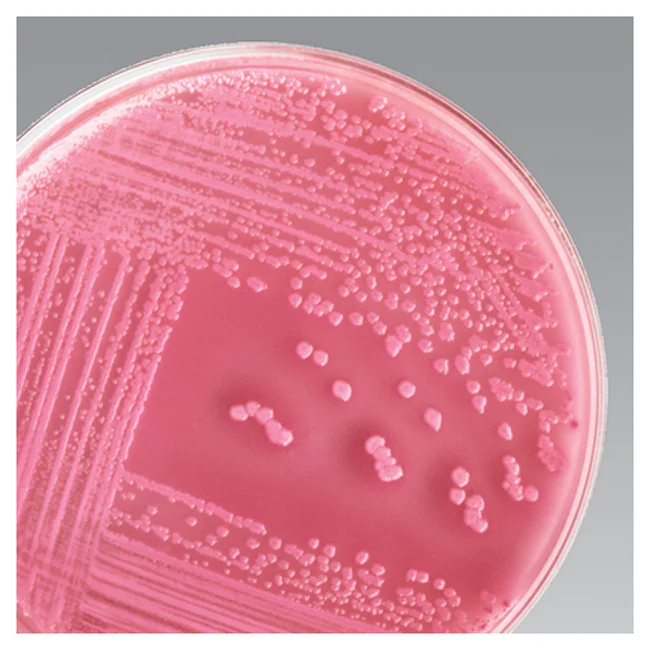
<p>MacConkey Agar (MAC)</p>

lab 15 and 16- gram negative bacilli/ family enterobacteriaceae and Urine culture
1/11
There's no tags or description
Looks like no tags are added yet.
Name | Mastery | Learn | Test | Matching | Spaced | Call with Kai |
|---|
No analytics yet
Send a link to your students to track their progress
12 Terms
Opportunistic pathogen
Commensals may still cause disease in humans if they are introduced into another area within the body, for instance into the urogenital tract.
Enterobacteriaceae
-gram negative bacilli
-facultative anaerobes
-oxidase negative
-acid production from glucose
-most are catalase positive
-most reduce nitrate(NO3) to nitrite (NO2)
-peritrichous flagella if motile

eosin methylene blue agar (emb)
selective for gram negative bacteria
differential for lactose fermenters; appear purple or purple pink; ecoli appear metallic green
MacConkey Agar (MAC)
Selective for gram negative bacteria
differential for lactose fermenters; usually appear as pink colonies
What is the difference between a true pathogen and an opportunistic pathogen?
True pathogens (primary pathogens) cause disease in healthy individuals with intact immune systems, whereas opportunistic pathogens cause infection only when host defenses are compromised,
What tests are typically performed to characterize gram negative bacilli?
Gram staining, oxidase, indole, citrate utilization, urease activity, and lactose fermentation on MacConkey agar
UTIs urinary tract infections
Infections of the urethra and urinary bladders
cystitis
the inflammation of the urinary bladder
preparing urine sampls
Columbia CNA
10 ul disposable inoculating loops
35 C until the next lab meeting
Dysuria
initial symptoms (painful and frequent urination)
pyuria
presence of leukocytes and pus in urine
pyelonephritis
an inflammation of the kidneys either one or both kidneys.